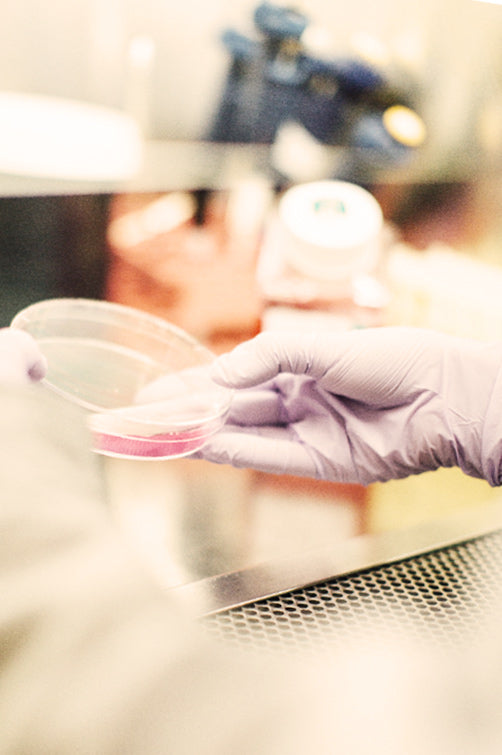

Lactose intolerance and camel milk. Is drinking camel milk safe?

Is Camel Milk Safe for People with Lactose Intolerance?
Camel milk has become an increasingly popular alternative for people who experience digestive discomfort with cow's milk. Unlike cow’s milk, camel milk lacks β-lactoglobulin, the primary allergen responsible for milk protein allergies, making it significantly less likely to trigger adverse reactions.
Studies indicate that individuals with lactose intolerance can digest camel milk more easily due to its lower lactose content and unique protein structure, potentially reducing symptoms such as bloating, gas, and diarrhea.

What Is Lactose Intolerance and How Common Is It?
Lactose intolerance occurs when the body lacks sufficient lactase enzyme to effectively break down lactose, the primary sugar found in milk. This inability results in unpleasant digestive symptoms, affecting up to 65% of adults globally, according to the World Health Organization (WHO). Symptoms frequently include:
- Bloating
- Gas
- Diarrhea
- Stomach cramps
This widespread condition prompts many individuals to seek alternative milk sources, such as camel milk, that offer nutritional benefits without discomfort.
At CamelWay, we believe in the extraordinary power of camel milk. Since 2019, we have proudly served the EU with premium camel milk products that redefine quality. Our selection of fresh camel milk and nutrient-rich camel milk powder is crafted to deliver unmatched taste and health benefits. Buy camel milk from CamelWay and experience a natural boost in nutrition and vitality every day.
-
Camel Milk Powder 300g | Pure & Nutritious
Vendor:CamelWayRegular price €54,95Regular priceUnit price / per€69,95Sale price €54,95Sale -
Camel Milk Powder 3x300g (Total 900g) | Family Bulk Pack
Vendor:CamelWayRegular price €149,95Regular priceUnit price / per€164,95Sale price €149,95Sale -
Handmade Camel Milk Chocolate | 44% Cocoa
Vendor:CamelWayRegular price €8,95Regular priceUnit price / per€12,95Sale price €8,95Sale -
Camel Milk Probiotics | 42 Lozenges
Vendor:CamelWayRegular price €29,95Regular priceUnit price / per€39,95Sale price €29,95Sale
Can Camel Milk Help Reduce Allergic Reactions Compared to Other Milks?
Research highlights that camel milk stands out as one of the least allergenic milk types available, second only to human breast milk. Unlike cow’s milk, camel milk does not contain β-lactoglobulin, the primary protein allergen linked to milk allergies.
Additionally, it has significantly lower lactose levels paired with a unique combination of proteins and minerals, making it easier to digest and less likely to cause allergic reactions. These unique properties position camel milk as an excellent choice for individuals sensitive to dairy who still wish to enjoy milk’s nutritional benefits.

What Nutritional Advantages Does Camel Milk Offer?
Beyond its hypoallergenic properties, camel milk boasts an impressive nutritional profile, packed with essential vitamins, minerals, immunoglobulins, and antioxidants. Key benefits include:
- Rich in vitamins C and B, calcium, iron, and potassium.
- Contains potent anti-inflammatory and antioxidant compounds.
- Supports gut health and boosts immunity, providing relief for individuals prone to digestive issues.
These qualities make camel milk an ideal addition to a balanced, health-conscious diet.

Lactoferrin in Camel Milk: Is Camel Milk a Good Substitute for Breast Milk?
Camel milk uniquely contains high concentrations of lactoferrin, a protein closely resembling that found in human breast milk. Lactoferrin offers potent antimicrobial, antiviral, and immune-boosting benefits, promoting overall health and potentially reducing the risk of infections and allergies.
Due to its close similarity to human breast milk, camel milk is increasingly recognized as a suitable supplementary option for infants and young children, particularly those sensitive to cow’s milk.

Why Should People with Lactose Intolerance Consider Camel Milk?
For those experiencing lactose intolerance, introducing camel milk into the diet offers several notable benefits:
- Easier digestion and fewer symptoms related to lactose intolerance.
- Maintains essential nutritional intake without the gastrointestinal distress typically associated with dairy.
- Provides a practical, natural, and delicious alternative for daily milk consumption.
As always, consulting a healthcare provider before dietary changes is advisable, especially for those with specific allergies or dietary restrictions.

How to Introduce Camel Milk into Your Daily Routine
Incorporating camel milk into your diet is easy and versatile:
- Use camel milk as a substitute in cereals, coffee, and smoothies.
- Bake and cook with camel milk powder for enhanced nutritional value.
- Regularly consume camel milk products, which promote gut health and support immunity.
Simple daily changes can significantly enhance your nutritional profile and overall health.

Start Your Journey with CamelWay Camel Milk
At CamelWay, our commitment extends beyond simply providing premium camel milk products. Our camels are meticulously cared for at our sustainable Dubai farm, ensuring every product meets the highest standards for quality and nutrition. When you choose CamelWay, you are investing in:
- Scientifically supported, premium-quality products.
- Ethical and sustainable production practices.
- Consistent nutritional benefits backed by thorough research.
Enhance your well-being today by experiencing the extraordinary benefits of camel milk with CamelWay.
Article sources and scientific research
- El-Agamy, E. I. (2007). Camel milk as an alternative to cow's milk for lactose-intolerant individuals: A review. International Journal of Dairy Science, 2(4), 261-271.
- Shabo, Y., Yagil, R., & Eti, S. (2005). Camel milk for food allergies in children. Israel Medical Association Journal, 7(12), 796-798.
- Faye, B., & Konuspayeva, G. (2012).
https://pubmed.ncbi.nlm.nih.gov/20857626/ - https://pubmed.ncbi.nlm.nih.gov/28100852/
- https://pubmed.ncbi.nlm.nih.gov/26767108/
- Camel milk: a possible alternative for children with cow's milk allergy? (PMID: 31692312)
https://pubmed.ncbi.nlm.nih.gov/31692312/ - Camel milk for food allergies in children (PMID: 16382703)
https://pubmed.ncbi.nlm.nih.gov/16382703/ - Camel Milk Is a Safer Choice than Goat Milk for Feeding Children with Cow Milk Allergy
https://www.ncbi.nlm.nih.gov/pmc/articles/PMC3658853/ - The Antioxidant, Anti-Inflammatory and Immunomodulatory Effects of Camel Milk
https://www.ncbi.nlm.nih.gov/pmc/articles/PMC9039309/ - Cross-over clinical trial for evaluating the safety of camel's milk intake in patients who are allergic to cow's milk protein (PMID: 29223706)
https://pubmed.ncbi.nlm.nih.gov/29223706/
Recommended products for you
-
Camel Milk Powder 300g | Pure & Nutritious
Vendor:CamelWayRegular price €54,95Regular priceUnit price / per€69,95Sale price €54,95Sale -
Camel Milk Powder 3x300g (Total 900g) | Family Bulk Pack
Vendor:CamelWayRegular price €149,95Regular priceUnit price / per€164,95Sale price €149,95Sale -
Handmade Camel Milk Chocolate | 44% Cocoa
Vendor:CamelWayRegular price €8,95Regular priceUnit price / per€12,95Sale price €8,95Sale -
Camel Milk Probiotics | 42 Lozenges
Vendor:CamelWayRegular price €29,95Regular priceUnit price / per€39,95Sale price €29,95Sale
About Camel Milk
View all-
Camel Milk Benefits: What Are Its Unique Proper...
Discover the unique health benefits of camel milk. This article dives into its proven properties - from improved digestion and heart health to potential support for diabetes and autism. Learn...
Camel Milk Benefits: What Are Its Unique Proper...
Discover the unique health benefits of camel milk. This article dives into its proven properties - from improved digestion and heart health to potential support for diabetes and autism. Learn...
-
Can Camel Milk Help Autism? We Checked the Late...
The existing scientific evidence supports camel milk as a potentially beneficial complementary therapy for autism. Its unique combination of anti-inflammatory, antioxidant, and immune-regulatory properties could significantly enhance life quality for...
Can Camel Milk Help Autism? We Checked the Late...
The existing scientific evidence supports camel milk as a potentially beneficial complementary therapy for autism. Its unique combination of anti-inflammatory, antioxidant, and immune-regulatory properties could significantly enhance life quality for...
-
Camel Milk and Diabetes: Benefits & Recent Scie...
Discover how camel milk significantly aids diabetes treatment by improving glycemic control and reducing insulin needs, supported by recent research findings.
Camel Milk and Diabetes: Benefits & Recent Scie...
Discover how camel milk significantly aids diabetes treatment by improving glycemic control and reducing insulin needs, supported by recent research findings.
-
Why Lactoferrin Makes Camel Milk a Health Super...
Why Lactoferrin Makes Camel Milk a Health Superstar When discussing superfoods, few people immediately think of camel milk. Yet, hidden within this unconventional milk is lactoferrin, a remarkable protein typically...
Why Lactoferrin Makes Camel Milk a Health Super...
Why Lactoferrin Makes Camel Milk a Health Superstar When discussing superfoods, few people immediately think of camel milk. Yet, hidden within this unconventional milk is lactoferrin, a remarkable protein typically...